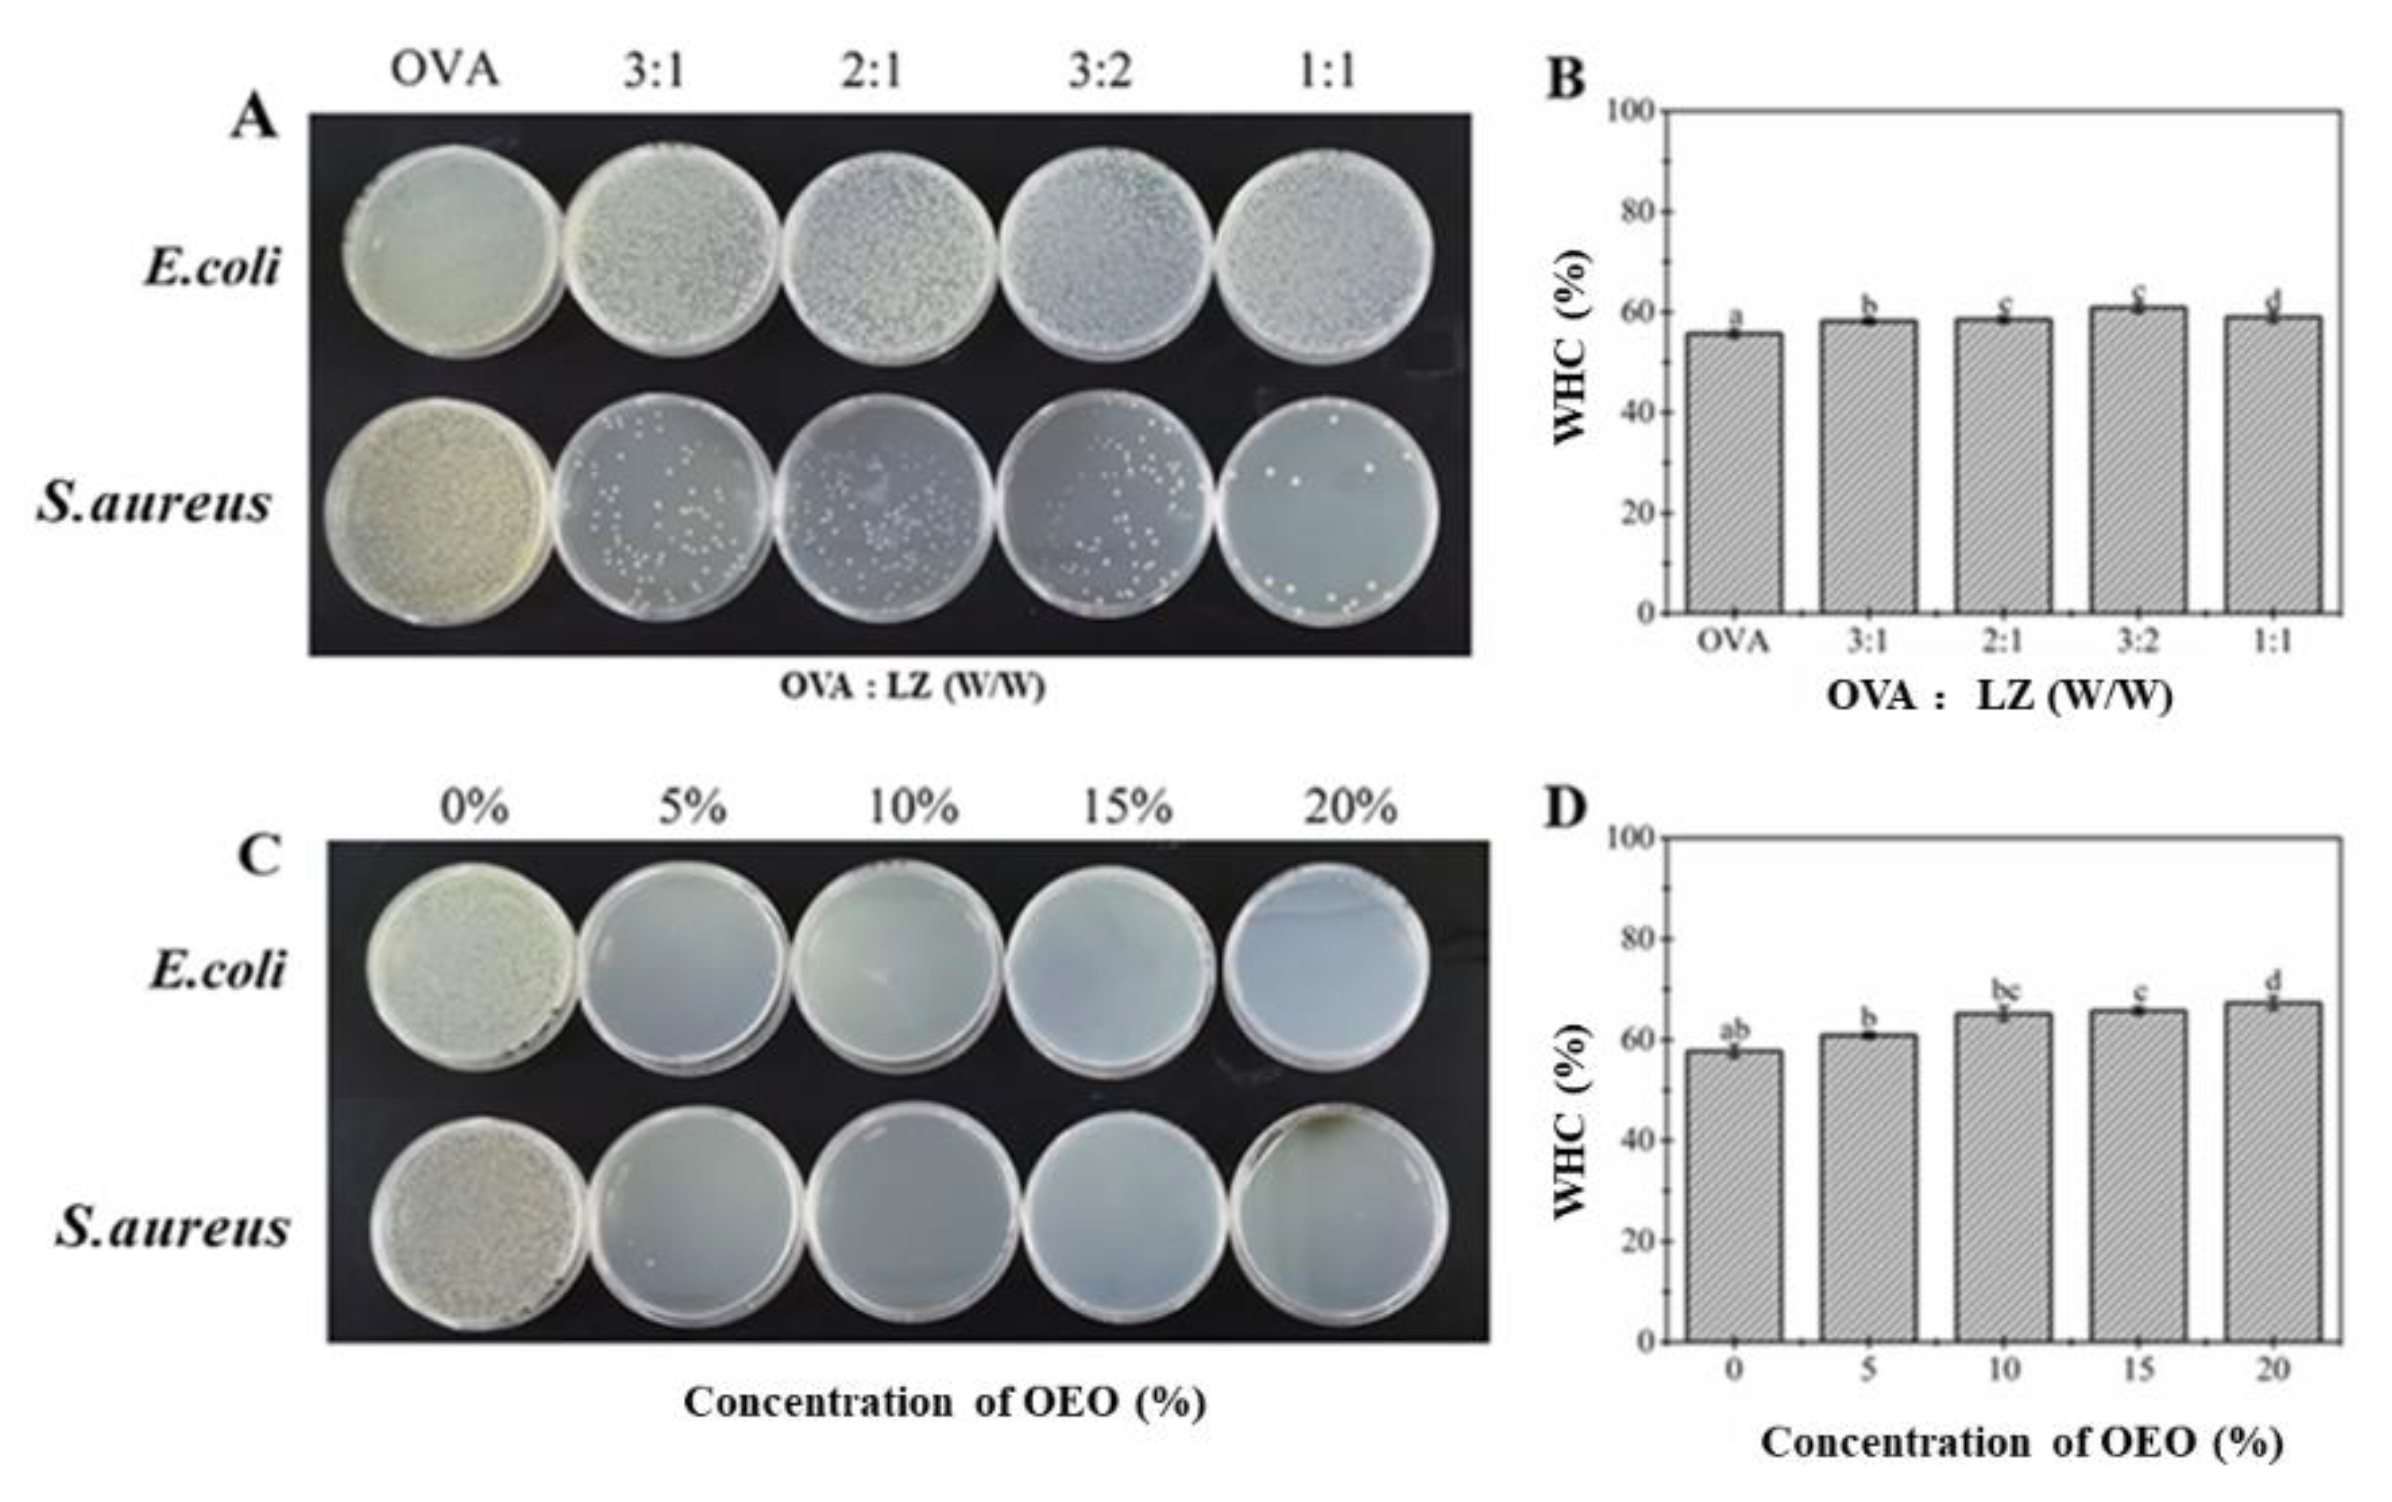
Gels 08 00838 g001
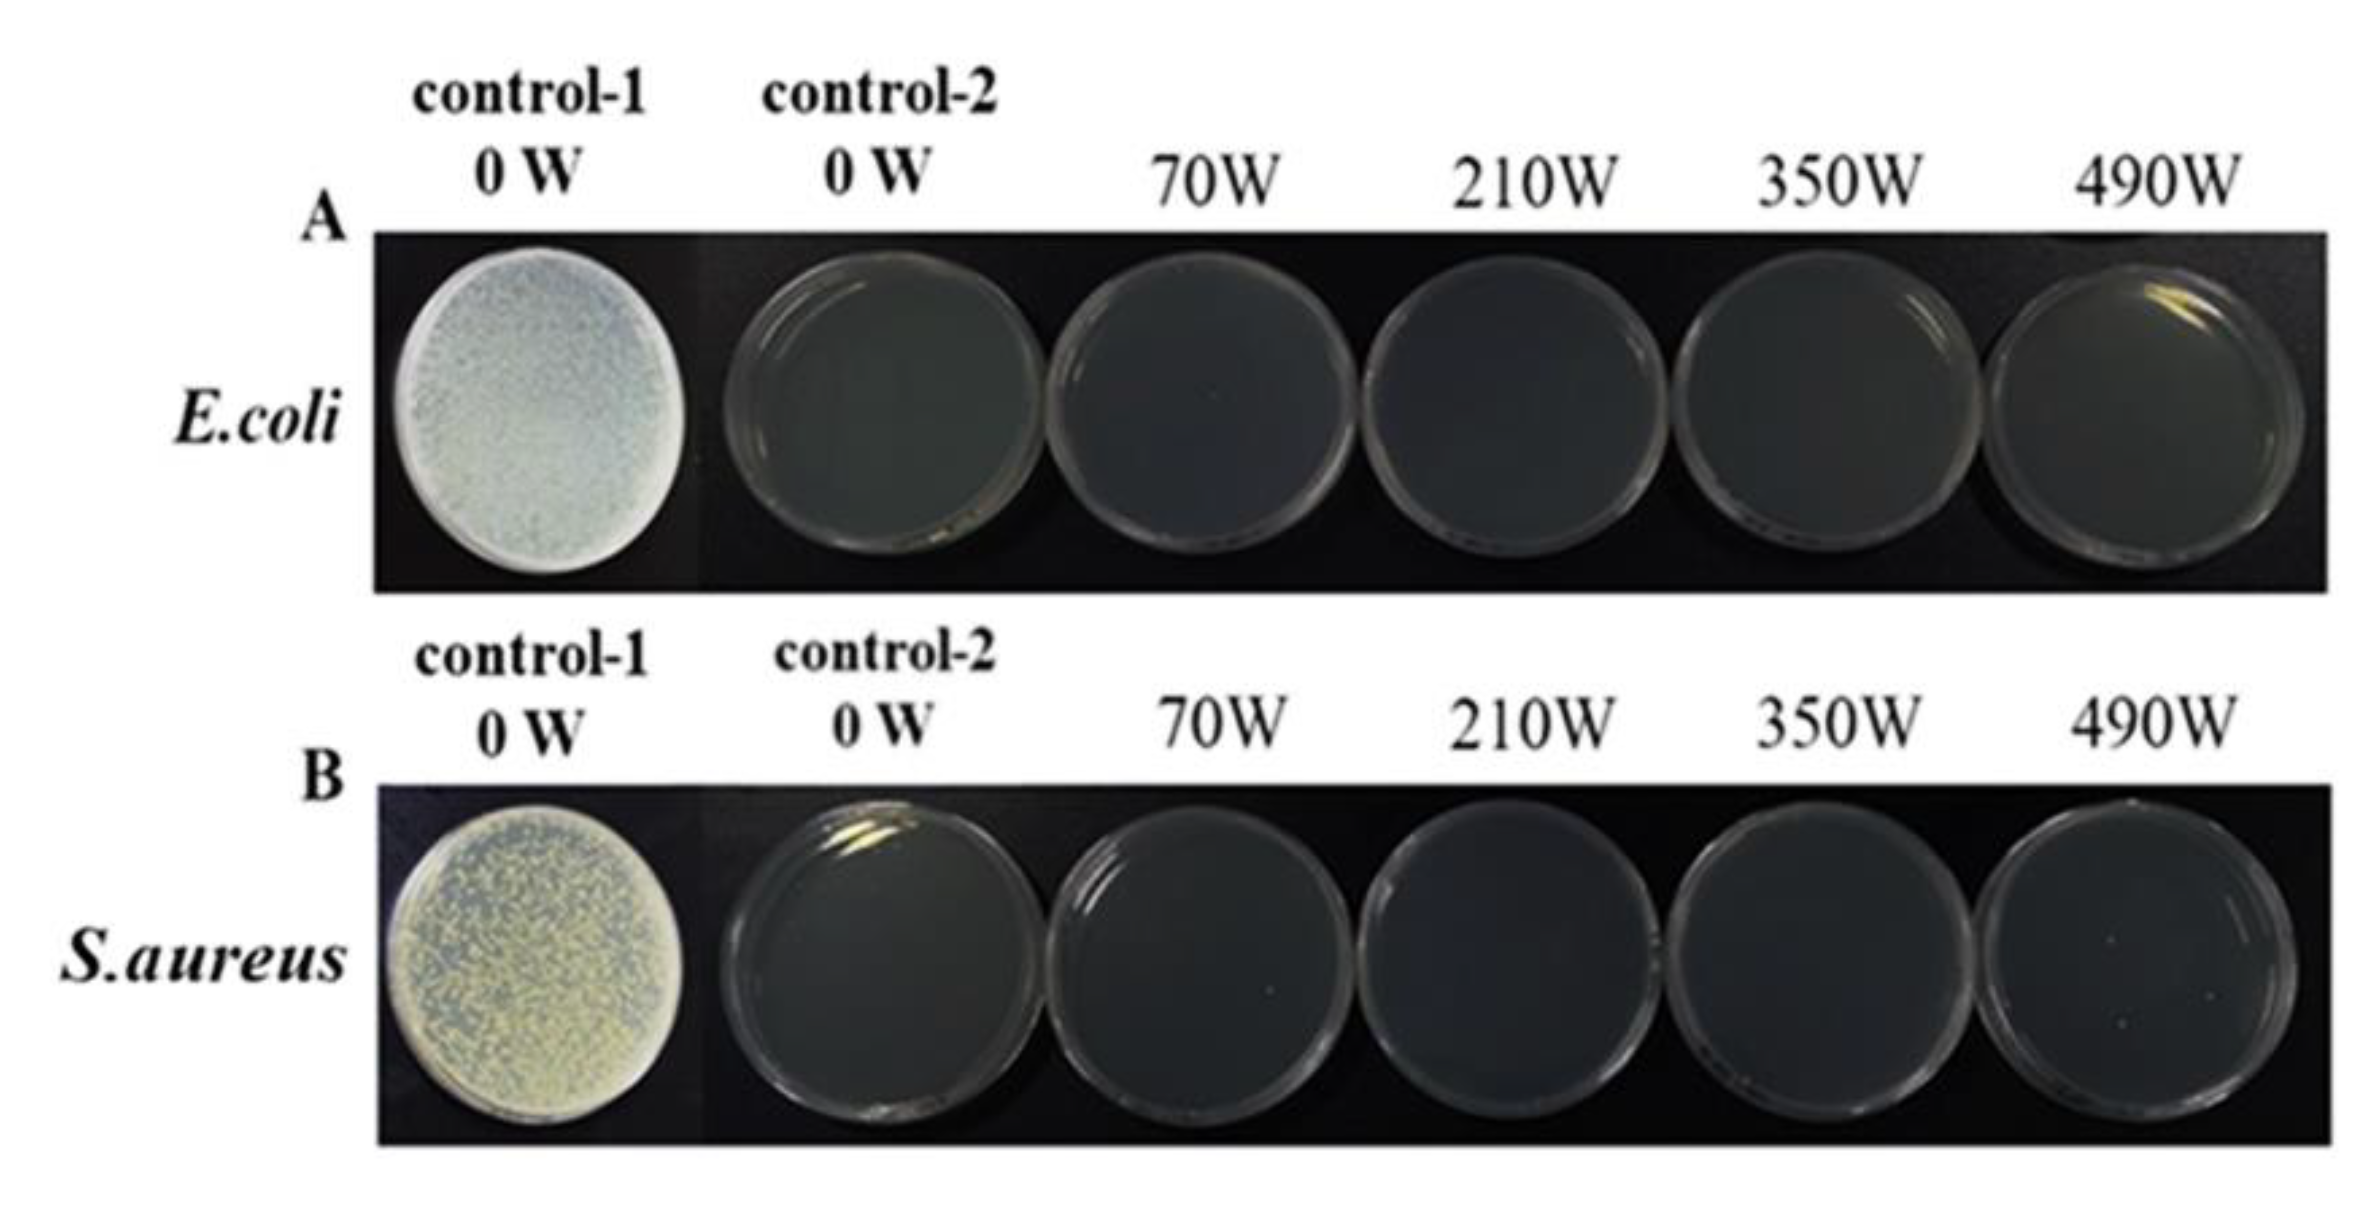
Gels 08 00838 g007

Preparation of an LZ-OEO Compound Antibacterial Gel and the Effect of Microwave Treatment on Its Structure and Stability
Abstract
1. Introduction
2. Results and Discussion
2.1. Study on the Antibacterial Gel Formulation of Lysozyme (LZ) and Oregano Essential Oil (OEO)
2.1.1. Addition of LZ
2.1.2. Addition of OEO
2.2. Effect of Microwave Treatment on the Hardness of LZ-OEO Antibacterial Gel
2.3. Effect of Microwave Treatment on the Moisture of the LZ-OEO Antibacterial Gel
2.3.1. Water-Holding Capacity of the Gel
2.3.2. Distribution of the Gel Moisture
2.4. Effect of Microwave Treatment on the Rheological Properties
2.5. Effect of Microwave Treatment on the Microstructure of LZ-OEO Antibacterial Gel
2.5.1. Confocal Laser Scanning Microscope (CLSM)
2.5.2. Transmission Electron Microscopy (TEM)
2.6. Effect of Microwave Treatment on the Antibacterial Property of the LZ-OEO Antibacterial Gel
3. Conclusions
4. Materials and Methods
4.1. Materials
4.2. Preparation of Antibacterial Gel
4.3. Determination of Gel Hardness
4.4. Determination of Water-Holding Capacity (WHC)
4.5. Low Field-Nuclear Magnetic Resonance (LF-NMR)
4.6. Determination of Rheological Properties
4.7. Observation of Gel Microstructure
4.7.1. Confocal Laser Scanning Microscope (CLSM)
4.7.2. Transmission Electron Microscope (TEM)
4.8. Determination of Bacteriostasis
4.9. Statistical Analysis
Author Contributions
Funding
Institutional Review Board Statement
Informed Consent Statement
Data Availability Statement
Acknowledgments
Conflicts of Interest
References
- Dickinson, E. Colloids in Food: Ingredients, Structure, and Stability. In Annual Review of Food Science and Technology; Annual Reviews; Doyle, M.P., Klaenhammer, T.R., Eds.; Palo Alto: Santa Clara, CA, USA, 2015; Volume 6, pp. 211–233. [Google Scholar] [CrossRef]
- Mao, L.K.; Lu, Y.; Cui, M.N.; Miao, S.; Gao, Y.X. Design of gel structures in water and oil phases for improved delivery of bioactive food ingredients. Crit. Rev. Food Sci. Nutr. 2020, 60, 1651–1666. [Google Scholar] [CrossRef]
- Geng, F.; Wang, J.Q.; Liu, D.Y.; Jin, Y.G.; Ma, M.H. Identification of N-Glycosites in Chicken Egg White Proteins Using an Omics Strategy. J. Agric. Food Chem. 2017, 65, 5357–5364. [Google Scholar] [CrossRef]
- Li, S.G.; Huang, Y.; An, F.P.; Huang, Q.; Geng, F.; Ma, M.H. Hydroxyl radical-induced early stage oxidation improves the foaming and emulsifying properties of ovalbumin. Poult. Sci. 2019, 98, 1047–1054. [Google Scholar] [CrossRef] [PubMed]
- Rao, S.Q.; Xu, G.W.; Lu, X.N.; Zhang, R.Y.; Gao, L.; Wang, Q.Y.; Yang, Z.Q.; Jiao, X.A. Characterization of ovalbumin-carvacrol inclusion complexes as delivery systems with antibacterial application. Food Hydrocoll. 2020, 105, 7. [Google Scholar] [CrossRef]
- Schaafsma, G.; Slavin, J.L. Significance of Inulin Fructans in the Human Diet. Compr. Rev. Food Sci. Food Saf. 2015, 14, 37–47. [Google Scholar] [CrossRef]
- Catauro, M.; Tranquillo, E.; Dal Poggetto, G.; Naviglio, S.; Barrino, F. Antibacterial Properties of Sol-Gel Biomaterials with Different Percentages of PEG or PCL. Macromol. Symp. 2019, 389, 1900056. [Google Scholar] [CrossRef]
- Liu, Z.H.; Luo, Y.P.; Zhao, X.M.; Zheng, K.Y.; Wu, M.H.; Wang, L.L. A natural antibacterial agent based on modified chitosan by hinokitiol for antibacterial application on cotton fabric. Cellulose 2022, 29, 2731–2742. [Google Scholar] [CrossRef]
- Behera, K.; Wani, F.A.; Bhat, A.; Juneja, S.; Banjare, M.K.; Pandey, S.; Patel, R. Behavior of lysozyme within ionic liquid-in-water microemulsions. J. Mol. Liq. 2021, 326, 10. [Google Scholar] [CrossRef]
- Li, S.Y.; Yang, X.; Zhang, Y.Y.; Ma, H.L.; Liang, Q.F.; Qu, W.J.; He, R.H.; Zhou, C.S.; Mahunu, G.K. Effects of ultrasound and ultrasound assisted alkaline pretreatments on the enzymolysis and structural characteristics of rice protein. Ultrason. Sonochemistry 2016, 31, 20–28. [Google Scholar] [CrossRef]
- Lee, J.H.; Yang, H.J.; Lee, K.Y.; Song, K.B. Physical properties and application of a red pepper seed meal protein composite film containing oregano oil. Food Hydrocoll. 2016, 55, 136–143. [Google Scholar] [CrossRef]
- Seydim, A.C.; Sarikus, G. Antimicrobial activity of whey protein based edible films incorporated with oregano, rosemary and garlic essential oils. Food Res. Int. 2006, 39, 639–644. [Google Scholar] [CrossRef]
- Zivanovic, S.; Chi, S.; Draughon, A.F. Antimicrobial activity of chitosan films enriched with essential oils. J. Food Sci. 2005, 70, M45–M51. [Google Scholar] [CrossRef]
- Lu, H.; Butler, J.A.; Britten, N.S.; Venkatraman, P.D.; Rahatekar, S.S. Natural Antimicrobial Nano Composite Fibres Manufactured from a Combination of Alginate and Oregano Essential Oil. Nanomaterials 2021, 11, 16. [Google Scholar] [CrossRef]
- Moraes-Lovison, M.; Marostegan LF, P.; Peres, M.S.; Menezes, I.F.; Ghiraldi, M.; Rodrigues RA, F.; Fernandes, A.M.; Pinho, S.C. Nanoemulsions encapsulating oregano essential oil: Production, stability, antibacterial activity and incorporation in chicken pate. Lwt-Food Sci. Technol. 2017, 77, 233–240. [Google Scholar] [CrossRef]
- Chang, C.H.; Su, Y.J.; Gu, L.P.; Li, J.H.; Yang, Y.J. Microwave induced glycosylation of egg white protein:study on physicochemical properties and baking performance. Food Hydrocoll. 2021, 118, 9. [Google Scholar] [CrossRef]
- Rombouts, I.; Wouters AG, B.; Lambrecht, M.A.; Uten, L.; Van den Bosch, W.; Vercruysse SA, R.; Delcour, J.A. Food protein network formation and gelation induced by conductive or microwave heating: A focus on hen egg white. Innov. Food Sci. Emerg. Technol. 2020, 66, 11. [Google Scholar] [CrossRef]
- Wang, Q.; Jiao, X.D.; Yan, B.W.; Meng, L.L.; Cao, H.W.; Huang, J.L.; Zhao, J.X.; Zhang, H.; Chen, W.; Fan, D.M. Inhibitory effect of microwave heating on cathepsin L-induced degradation of myofibrillar protein gel. Food Chem. 2021, 357, 9. [Google Scholar] [CrossRef] [PubMed]
- Zhu, M.M.; Peng, Z.Y.; Lu, S.; He, H.J.; Kang, Z.L.; Ma, H.J.; Zhao, S.M.; Wang, Z.R. Physicochemical Properties and Protein Denaturation of Pork Longissimus Dorsi Muscle Subjected to Six Microwave-Based Thawing Methods. Foods 2020, 9, 16. [Google Scholar] [CrossRef] [PubMed]
- Qin, X.S.; Luo, S.Z.; Cai, J.; Zhong, X.Y.; Jiang, S.T.; Zheng, Z.; Zhao, Y.Y. Effects of microwave pretreatment and transglutaminase crosslinking on the gelation properties of soybean protein isolate and wheat gluten mixtures. J. Sci. Food Agric. 2016, 96, 3559–3566. [Google Scholar] [CrossRef]
- Cheng, X.J.; Li, M.Y.; Wang, H.; Cheng, Y.Y. All-small-molecule dynamic covalent gels with antibacterial activity by boronate-tannic acid gelation. Chin. Chem. Lett. 2020, 31, 869–874. [Google Scholar] [CrossRef]
- Malhotra, K.; Singh, Y. Antibacterial Polymeric and Peptide Gels/Hydrogels to Prevent Biomaterial-Related Infections. Racing Surf. 2020, 96, 543–581. [Google Scholar] [CrossRef]
- Eslahi, N.; Abdorahim, M.; Simchi, A. Smart polymeric hydrogels for cartilage tissue engineering: A review on the chemistry and biological functions. Biomacromolecules 2016, 17, 3441–3463. [Google Scholar] [CrossRef]
- Akyuz, E.; Sen, F.B.; Bener, M.; Bakan, K.S.; Apak, R. A novel gold nanocluster-based fluorometric biosensor for measuring prooxidant activity with a large Stokes shift. Talanta 2020, 208, 7. [Google Scholar] [CrossRef]
- Jin, Y.G.; Zeng, Q.; Geng, F.; Ma, M.H. Characterization of the interaction between hen egg white lysozyme and ovalbumin Interaction between lysozyme and ovalbumin. Food Biosci. 2020, 36, 8. [Google Scholar] [CrossRef]
- Li, S.G.; Wang, K.P.; Huang, Q.; Geng, F. Microwave pretreatment enhanced the properties of ovalbumin-inulin-oil emulsion gels and improved the storage stability of pomegranate seed oil. Food Hydrocoll. 2021, 113, 10. [Google Scholar] [CrossRef]
- Pure, A.E.; Yarmand, M.S.; Farhoodi, M.; Adedeji, A. Microwave treatment to modify textural properties of high protein gel applicable as dysphagia food. J. Texture Stud. 2021, 52, 638–646. [Google Scholar] [CrossRef]
- Ji, L.; Xue, Y.; Zhang, T.; Li, Z.J.; Xue, C.H. The effects of microwave processing on the structure and various quality parameters of Alaska pollock surimi protein-polysaccharide gels. Food Hydrocoll. 2017, 63, 77–84. [Google Scholar] [CrossRef]
- Shaarani, S.M.; Nott, K.P.; Hall, L.D. Combination of NMR and MRI quantitation of structure and structure changes for convection cooking of fresh chicken meat. Meat Sci. 2006, 72, 398–403. [Google Scholar] [CrossRef]
- Wu, M.G.; Fei, L.T.; Zhuang, T.; Lei, S.M.; Ge, Q.F.; Yu, H.; Wang, J.H.; Wang, Y.S. Rheology and microstructure of myofibrillar protein-olive oil composite gels: Effect of different non-meat protein as emulsifier. J. Sci. Food Agric. 2018, 98, 799–806. [Google Scholar] [CrossRef] [PubMed]
- Wang, X.; Gu, L.P.; Su, Y.J.; Li, J.H.; Yang, Y.J.; Chang, C.H. Microwave technology as a new strategy to induce structural transition and foaming properties improvement of egg white powder. Food Hydrocoll. 2020, 101, 8. [Google Scholar] [CrossRef]
- Ma, M.S.; Zhong, Y.L.; Jiang, X.L. Thermosensitive and pH-responsive tannin-containing hydroxypropyl chitin hydrogel with long-lasting antibacterial activity for wound healing. Carbohydr. Polym. 2020, 236, 12. [Google Scholar] [CrossRef] [PubMed]
- Nicolai, T.; Chassenieux, C. Heat-induced gelation of casein micelles. Food Hydrocoll. 2021, 118, 6. [Google Scholar] [CrossRef]
- Aguilar-Mendez, M.A.; Espinosa-Solares, T.; Guerrero-Toledo, F.D.; Canseco-Gonzalez, D.; Velazquez-Hernandez, A.; Aguilar-Moreno, G.S.; Navarro-Ceron, E. Synthesis and characterisation of magnetite nanoparticles using gelatin and starch as capping agents. Iet Nanobiotechnology 2020, 14, 94–97. [Google Scholar] [CrossRef] [PubMed]

| Gel | T2b (ms) | T21 (ms) | T22 (ms) | A2b (a.u.) | A21 (a.u.) | A22 (a.u.) |
|---|---|---|---|---|---|---|
| control | 7.62 ± 0.83 a | 67.80 ± 0.49 a | 714.68 ± 39.41 a | 107.90 ± 1.07 a | 1106.18 ± 9.77 a | 5513.08 ± 50.10 a |
| 70 W | 8.04 ± 1.05 a | 70.52 ± 0.15 a | 732.66 ± 49.94 a | 126.99 ±1.20 ab | 1374.25 ± 29.74 b | 6917.94 ± 49.94 b |
| 210 W | 8.47 ± 0.27 a | 74.02 ± 0.10 a | 755.15 ± 45.52 a | 136.51 ± 0.10 b | 1631.64 ± 19.82 c | 7164.39 ± 45.52 b |
| 350 W | 8.24 ± 0.25 a | 74.02 ± 0.61 a | 778.45 ± 34.10 a | 137.20 ± 0.10 ab | 1669.60 ± 16.93 c | 7480.75 ± 34.10 b |
| 490 W | 8.18 ± 0.47 a | 72.10 ± 0.10 a | 755.15 ± 32.41 a | 125.28 ± 0.10 ab | 1495.41 ± 18.19 bc | 7305.04 ± 32.41 b |
Publisher’s Note: MDPI stays neutral with regard to jurisdictional claims in published maps and institutional affiliations. |
© 2022 by the authors. Licensee MDPI, Basel, Switzerland. This article is an open access article distributed under the terms and conditions of the Creative Commons Attribution (CC BY) license (https://creativecommons.org/licenses/by/4.0/).
Share and Cite
Wei, S.; Gao, Y.; Ma, L.; Wang, Z.; Liu, X.; Liu, Y.; Zhong, M.; Dong, S.; Li, S. Preparation of an LZ-OEO Compound Antibacterial Gel and the Effect of Microwave Treatment on Its Structure and Stability. Gels 2022, 8, 838. https://doi.org/10.3390/gels8120838
Wei S, Gao Y, Ma L, Wang Z, Liu X, Liu Y, Zhong M, Dong S, Li S. Preparation of an LZ-OEO Compound Antibacterial Gel and the Effect of Microwave Treatment on Its Structure and Stability. Gels. 2022; 8(12):838. https://doi.org/10.3390/gels8120838
Chicago/Turabian StyleWei, Shuaishuai, Ying Gao, Lulu Ma, Zhan Wang, Xin Liu, Ying Liu, Mengzhen Zhong, Shijian Dong, and Shugang Li. 2022. "Preparation of an LZ-OEO Compound Antibacterial Gel and the Effect of Microwave Treatment on Its Structure and Stability" Gels 8, no. 12: 838. https://doi.org/10.3390/gels8120838
APA StyleWei, S., Gao, Y., Ma, L., Wang, Z., Liu, X., Liu, Y., Zhong, M., Dong, S., & Li, S. (2022). Preparation of an LZ-OEO Compound Antibacterial Gel and the Effect of Microwave Treatment on Its Structure and Stability. Gels, 8(12), 838. https://doi.org/10.3390/gels8120838

